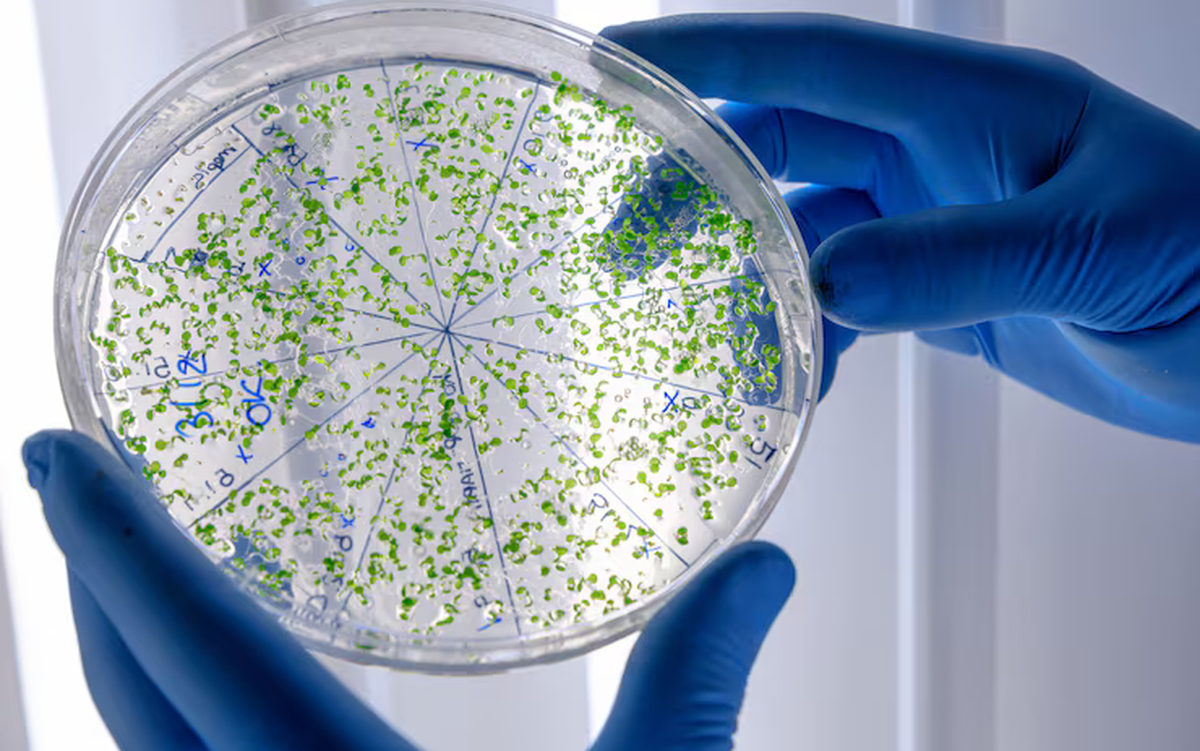

| Tin tức về: |
| Thứ Tư, 17/12/2025 - 08:28 | |
| AI tìm ra 'tử huyệt' ngăn vi rút xâm nhập tế bào | |
| Nhờ AI, các nhà khoa học Mỹ phát hiện 'công tắc' phân tử then chốt, vô hiệu hóa vi rút herpes ngay khi vừa tìm cách xâm nhập tế bào....Xem tiếp>>> |
| Tin tức mới nhất về Mỹ>>> Du lịch Mỹ>>> | |
Tin tức mới nhất về Mỹ
- Mỹ nhân gốc Việt Chung Lệ Đề và 3 con gái: Ai nấy đều xinh đẹp như hoa, trông chẳng khác chị em 20 phút trước
- Nhóm tác chiến siêu tàu sân bay Mỹ nằm trong phạm vi tấn công nhanh Venezuela 33 phút trước
- Chuyện gì đang kéo đồng USD đi xuống? 33 phút trước
- Trưởng nam nhà Trump đính hôn mỹ nhân Palm Beach 1 giờ trước
- Công ty của Elon Musk bị kết án “tiếp thị lừa đảo” 1 giờ trước
- 3 giọng ca Vpop tạo hiệu ứng quốc tế 2025 1 giờ trước
- Nhân viên nhà hàng Mỹ cứu mạng khách quen 1 giờ trước
- Tổng thống Mỹ Trump tuyên bố phong tỏa các tàu chở dầu ra, vào Venezuela 2 giờ trước
- Mỹ ‘ngậm đắng nuốt cay’ đánh mất kho báu 2 tỷ USD trải rộng bằng 1.820 sân bóng đá giữa sa mạc: Công nghệ đỉnh cao thế giới tụt hậu sau vài năm, đốt tiền tỷ không sinh lời 2 giờ trước
- Công ty liên quan bà Trương Mỹ Lan kiến nghị được tiếp tục thực hiện dự án Khu phức hợp Nhà Rồng - Khánh Hội 11.000 tỷ 2 giờ trước
Tin tức về Văn hóa
- Trao giải thưởng văn học TP.HCM 2025 16 phút trước
- Đại tiệc thời trang có HIEUTHUHAI và dàn nghệ sĩ “Say Hi“ tham gia gây hụt hẫng 33 phút trước
- Những dự án, tổ chức nào xứng đáng vinh danh Hành động vì Cộng đồng năm 2025? 4 giờ trước
- 44 tuổi chưa kết hôn nhưng “họa mi tóc nâu“ quê Đà Nẵng vẫn “hack tuổi“ với sắc vóc đẹp 11 giờ trước
- Á hậu Hoàn vũ từ bỏ danh hiệu đến Việt Nam 16 giờ trước
- Ngoại hình điển trai như nam thần Hàn Quốc của VĐV võ thuật gây sốt SEA Games 17 giờ trước
- Hồ Ngọc Hà ghi điểm khi “đụng“ váy trăm triệu đồng với Lisa 21 giờ trước
- Nhạc sĩ Nguyễn Văn Chung, HIEUTHUHAI và đoàn nghệ sĩ thăm căn cứ Rừng Sác Cần Giờ 21 giờ trước
- Mộ cụ phó bảng Nguyễn Sinh Sắc được xếp hạng di tích quốc gia đặc biệt 23 giờ trước
- Người phụ nữ chi hơn 29 tỷ đồng phẫu thuật thẩm mỹ để giống Phạm Băng Băng 1 ngày trước